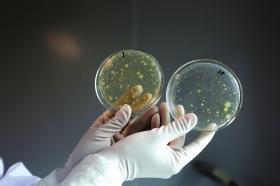
Can Hot Tubs Make You Sick

Facts about legionella and hot tubsspas what is legionella and how does it affect me.

Legionnaires disease hot tubs.
There are no vaccines that can prevent legionnaires disease.
The bubble aeration in a spa makes this more likely to happen and there have been cases of legionnaires disease that have been traced back to spas or hot tubs although domestic showers are also a risk.
Hot tubs that are not cleaned and disinfected properly can become contaminated with the bacteria.
Each year 800018000 people in the united states are hospitalized with legionnaires disease.
After all no one wants to get their friends and families sick.
In the same week that the courts have confirmed that a prosecution for corporate manslaughter will go ahead for bosses of jtf wholesale after two men died from legionnaires disease contracted from a display hot tub in one of their stores the health safety executive has published updated guidance on control of legionella in spa pools.
Legionnaires disease in spa pools and hot tubs and the risk of infection.
You do not have to be in the hot tub legionnaires disease can be caught by just standing nearby.
Infectious water borne agents can be easily introduced in to a spa pool from a variety of sources including bathers dirt entering the hot tub and from the water itself.
Instead the key to preventing legionnaires disease is to make sure that building owners and managers maintain building water systems in order to reduce the risk of legionella growth and spread.
Hot tubs spa baths and even garden hose pipes could harbour potentially lethal bacteria that causes legionnaries disease a leading charity has warned.
Many hot tub owners worry about legionnaires disease in their spas.
So you dont have to be sitting in the hot tub to inhale the bacteria.
However dont ever believe that you shouldnt use your hot tub anymore simply because there is a risk of contracting this illness.
Legionella lee juh nell a is a germ that can cause a type of pneumonia called legionnaires disease.
The truth is your chances are very low and you are more at risk in public hot tubs than your own personal hot tub.
Legionella can also be found in cooling towers plumbing systems and decorative pools or fountains.

Hot Tubs At Two Hotels Closed After Deadly Legionnaire Outbreak

Legionnaires Bug Found In Playboy Mansion Hot Tub After 123

Legionnaires Disease

Three Men Killed By Legionnaires Disease Caught From Garden

Safeguarding Your Guests Against Legionella Bacteria

Hot Tub Could Be Source Of Legionnaires Outbreak Telegraph

Could The Hot Tub At The Gym Give You Legionnaires Disease

Legionnaires Disease On The Rise Prevent It Naturally Dr

Hot Tub Legionnaires Disease Deaths Lead To Manslaughter Charges

Majorca Hotel Jacuzzi Is Source Of Legionnaires Disease

Legionnaires Disease In Northern Nj A Possible Link To

Playboy Mansion Hot Tub Bacteria Spawned Legionnaires

How To Test Personal Hot Tubs For Legionnaires

Legionnaires Disease What You Need To Know Mnn Mother

Beware Of Contracting Legionnaires Disease While On Vacation

Legionnaires Disease Legionnaire S Disease Attorneys

Legionella In Spas And Hot Tubs Sundance Spas

How Hot Tubs Can Harbour Legionnaires Bacteria Bbc News

Hse Guidance On Legionella Control In Pools Spas Pioneer

Officials Investigating After Nine Former Hotel Guests

Legionella The Hidden Danger Lurking In Garden Centres

Legionellosis Cluster At Horse Racetrack Traced To Hot Tub

Legionnaires Disease Vitalsigns Cdc

Prevention Of Legionnaires Disease Legionella Cdc

Vital Signs Deficiencies In Environmental Control

Diseases In Hotel Pools Hot Tubs

Diy Chain Fined 1m After Legionnaires Disease Outbreak

Legionella Legionnaires Disease Hot Tubs

Serious Disease Which People Catch From Air Conditioning And

Beware Of Contracting Legionnaires Disease While On Vacation

11 Sickened 1 Dead In New Hampshire Legionnaires Outbreak

Ymca Hot Tub In Waco Texas Investigated In Legionnaires

Hot Tub Is Source Of Florida Outbreak Legionnaires

What You Need To Know About Legionnaires Disease News

Hot Tubs And Hose Pipes Could Cause Deadly Legionnaires

Inflatable Hot Tub Health Risks Hot Tub Rash Inflatable

Woman Dies Of Legionnaires Disease Contracted From

Bureau Veritas Advises Hot Tub Owners To Be Vigilant As

What Is Legionnaires Disease

Can Hot Tubs Make You Sick Fox News

Update 12 Confirmed Legionnaires Disease Cases In Hampton

How To Avoid And Treat Legionnaires Disease From A Hot Tub

Days Inn Of Casselton Focus Of Inquiry Into 3 Illnesses

The Deadly Disease That Could Be Hiding In Your Hot Tub And

Hot Tub Legionnaires Case Leads To 1m Fine For Discount

Hot Tub Wikipedia

Legionnaires Disease Cruise Ship Outbreak

Hot Tubs And Hose Pipes Could Cause Deadly Legionnaires

Can Hot Tubs Make You Sick

Diy Chain Whose Filthy Hot Tub Sparked Legionnaires Disease

Three Killed By Legionnaires Disease From Garden Centre S

Hot Tub Legionnaires Disease Deaths Lead To Manslaughter Charges

Whirlpool Hot Tub At Waco Family Ymca Investigated For

Michael Rosenfield Nbc10 Boston On Twitter This Is

Inflatable Hot Tub Health Risks Legionnaires Disease

Final Report On Legionnaires Outbreak In Hampton Says Up To

Hotel Hot Tubs Contain Deadly Germs Including Feces And

What Everyone Needs To Know About Legionnaires Disease

5 Weird Ways Hot Tubs Can Make You Sick Live Science

Manslaughter Charges For Diy Warehouse As 3 Die From

Three Killed By Legionnaires Disease From Garden Centre S

How Safe Are Hot Tubs Wsj

Legionnaires Disease At Waco Hotel Under Investigation

Legionnaires Disease In Spa Pools Hot Tubs Jacuzzis

Ymca Hot Tub In Waco Texas Investigated In Legionnaires

7 Cases Of Legionnaires Disease Tied To Las Vegas Rio

Jacuzzi And Hot Tub Legionnaires Disease Risks Hbe News

Health Spa Is Shut Down After Hot Tub Outbreak Of

Legionnaires Disease Outbreak In Staffordshire Blamed On

Legionnaires Disease Discovered In Milwaukee County

Legionella Bacteria Found In Penthouse Hot Tub At Lapland

Legionnaires Disease Wikipedia

Legionella Hot Tub Party Water Hygiene Experts 01789 270710

Germ Alert Hot Tub Germs Special Edition Kimcampion Com

Public Spas And Hot Tubs Draw Scrutiny With Recent

New Hse Legionella Guidance For Hot Tubs

Dirty Hot Tub In Diy Store Causes Legionnaires Disease

Health Class Storyboard Legionnaires Storyboard

British Tourist Died From Legionnaires Disease Outbreak

Hot Tubs Shut Down During Legionnaires Investigation Weren

Legionella Risk Assessments Dumfries Cumbria Solway

Legionella National Environmental Health Association Neha

Hot Tubs And Legionella Private Residential Hot Tubs

Legionnaires Disease Ac Systems Cooling India Monthly

Legionnaires Outbreak Caused By Poor Maintenance Of Sands

Legionnaires Disease What Is It And What Are The Symptoms

Waco Family Y Closes Hot Tub Amid Legionnaires

Hot Tub Legionellosis Legionnaires Disease And Pontiac

What Is Legionella Disease Legionella

What Deadly Bacteria Lies In Your Swimming Pool From

Hot Tubs Caused Legionnaires Outbreak Killing At Least 32

Legionnaires Disease Legionnaires Outbreak Atlanta

How Hot Tub Users Risk Legionnaires Disease Holiday

Hot Tub At Retirement Community Tests Positive For Legionnaires Disease

How To Avoid And Treat Legionnaires Disease From A Hot Tub

Can You Catch Legionnaires Disease From A Shower

How Legionella Affects Building Water Systems And People

Health Spa Is Shut Down After Hot Tub Outbreak Of